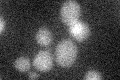
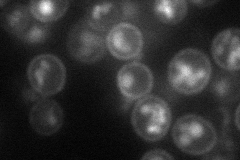
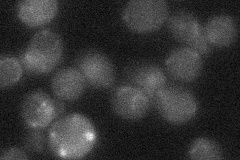
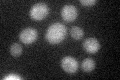

View description
Plasma membrane low glucose sensor that regulates glucose transport; contains 12 predicted transmembrane segments and a long C-terminal tail required for induction of hexose transporters; also senses fructose and mannose; similar to Rgt2p
Localization:
Intensity:
Fold change:
Significance:
-
C’ GFP library in SD
below threshold13.69 -
N' NOP1pr-GFP in SD

cell periphery32.7424 -
N' TEF2pr-mCherry in SD
cell periphery,vacuole41.2798 -
N' NATIVEpr-GFP in SD
below threshold17.9449 -
N' TEF2pr-VC and Cyto-VN in SD

below threshold25.3209 -
C’ GFP library in SD+DTT
cytosol14.51.05No -
C’ GFP library in SD+H2O2

cytosol16.071.17No -
C’ GFP library in Starvation Media

cytosol16.541.2No -
C’ GFP library on the background of Pup2-DaMP

below threshold -
C’ GFP library on the background of CCT mutant

below threshold14.23771.03899No
